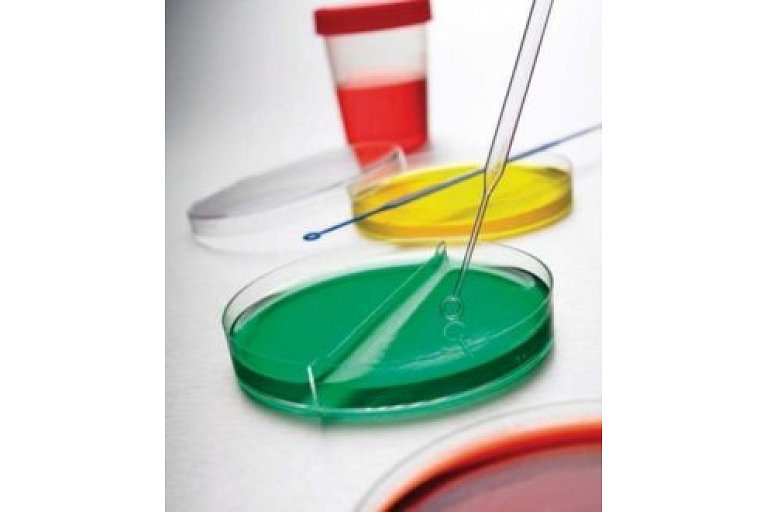

Images for search "-teika"

Stone processing, tombstones, grave stones Stone processing, tombstones, grave stones
"Efeja RS", LTD, Funeral services office

Stone processing, tombstones, grave stones Stone processing, tombstones, grave stones
"Efeja RS", LTD, Funeral services office

Stone processing, tombstones, grave stones Stone processing, tombstones, grave stones
"Efeja RS", LTD, Funeral services office

Stone processing, tombstones, grave stones Stone processing, tombstones, grave stones
"Efeja RS", LTD, Funeral services office

Stone processing, tombstones, grave stones Stone processing, tombstones, grave stones
"Efeja RS", LTD, Funeral services office

Funeral wreaths, crowns, funeral bouquets, flowers Funeral wreaths, crowns, funeral bouquets, flowers
"Efeja RS", LTD, Funeral services office